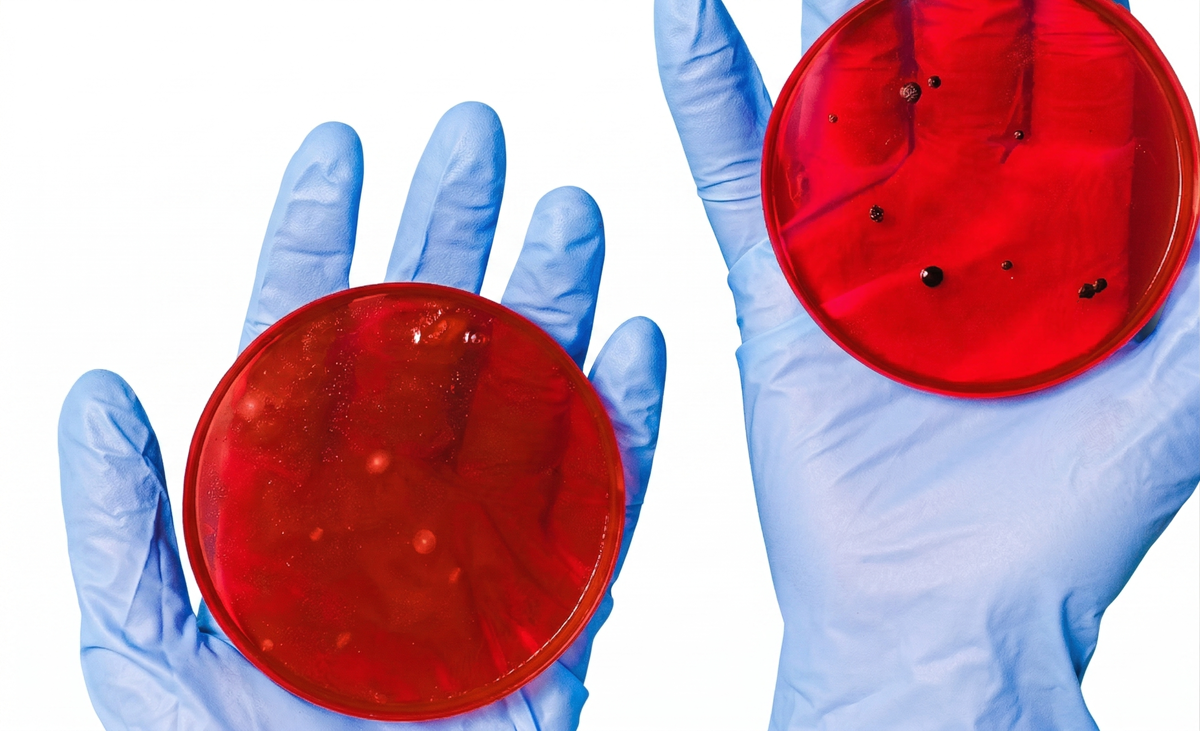
Placas de Petri en análisis

En algunas preparaciones farmacéuticas o cosméticas, fundamentalmente en fórmulas líquidas y semisólidas acuosas, es necesario el uso de conservantes que prevengan la proliferación microbiana durante el periodo de validez del producto.
El uso de conservantes ha de estar justificado y su concentración ha de ser la mínima que garantice su eficacia a lo largo de toda la vida del producto; por ello también se debe verificar la eficacia de los conservantes al final del periodo de validez del producto.